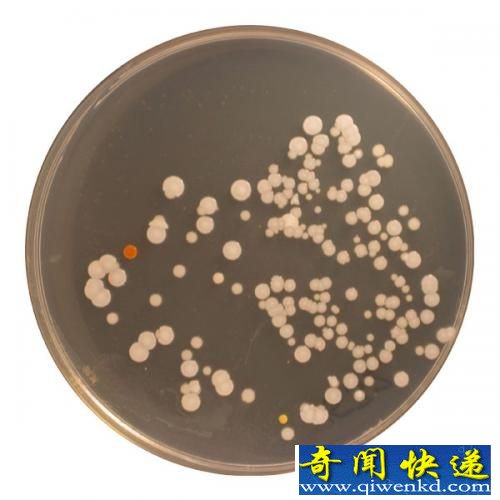
꺬67ֲͬϸ

人类肚脐含有67种不同细菌

你想过这里居住着什么生物吗?
研究发现的大部分微生物种类都属于微球菌属(Micrococcus),为放线菌的种类。
新浪奇闻快递北京时间11月13日消息,科学家已经知道我们肚脐里最常见的细菌种类,但不同人的肚脐里细菌种类是否相同?是什么在影响细菌种类的变化?这些都是北卡罗来纳州立大学的罗布·邓恩博士想要解决的问题。作为“肚脐生物多样性”项目的负责人,以下就是他最近的研究成果。
研究者用棉签从66位参与者的肚脐上擦拭取下样品,然后通过高通量基因测序确定每个样品里的微生物种类(或称种系型,phylotype),以及这些微生物的出现频率。此项研究中,只要16s rDNA(脱氧核糖核酸重组体)序列与其他种类的差异在3%以上,就可以确定为新的生物体。从这个意义上说,16s rDNA就像是微生物的基因指纹。
研究者发现了成千上万的微生物,但只有一小部分是在人群里常见,绝大多数种类都只出现了一两次。具体来说,研究中一共发现了2368种微生物,包括首次发现的3种古菌。然而,只有8种细菌在70%以上的实验者身上都有发现。这8种细菌也是数量最丰富的种类,几乎占了样品细菌总量的一半。
“最常见,而且数量最大的种类来自于一个相对少数的进化路线,表明它们已经进化出了适应在人类皮肤上生活的特征,”邓恩说,“然而,我们依旧不知道这些种类是否会在特定的人身上出现。我们分析了性别、年龄、种族以及其他许多因素,但都不能预测出某个人身上会出现什么细菌。”
研究者们之所以提出“肚脐生物多样性”项目,很大一部分原因是,近几年来对人体体表微生物的研究已经发现,这些微生物是人体对抗疾病的第一道防线。“我们知道,没有了这些微生物,我们的免疫系统就不能正常工作,”邓恩说,“事实上,这些微生物应该具有特定的种类组成,即形成某种微生物生态系统,以利于人体免疫系统正常运作。这项工作将有助于我们了解哪些种类在这些生态系统中最为重要。”
至于为什么选择从肚脐采样,研究者给出了两个答案。首先,这是人身体上一个受外界影响很小的代表部位;其次,研究者希望能够让公众参与到科学研究中来。“研究肚脐一听起来就很搞笑,”邓恩说,“这会抓住人们的眼球。”
研究人员发现,实验者的肚脐中平均有67种不同的细菌,而且其中很多细菌的发现相当意外,有些基本上只在海洋环境和外国土地上才能发现。有关这一研究的论文在线发表在《PLOS-ONE》上
精彩文章:雷击事件 玛雅考古重大新发现 白矮星 黄唇鱼